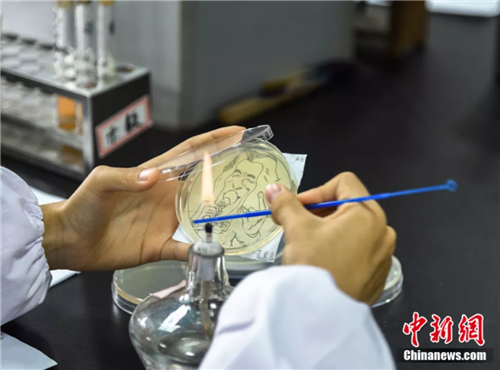
还不能忽视对应培养基的使用方式
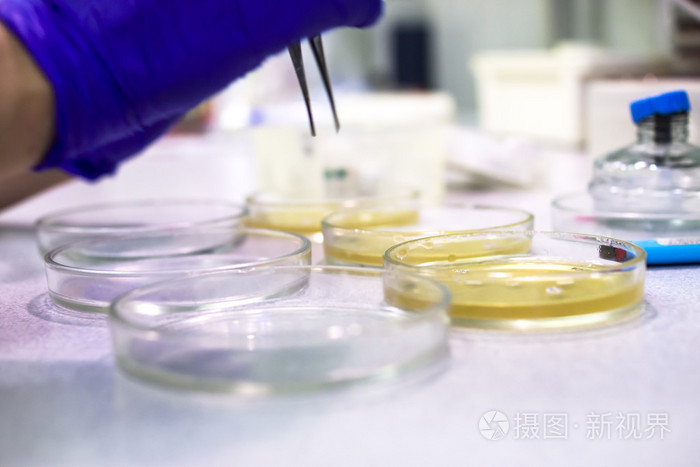
科学家使用在实验室的培养皿

培养皿的使用方法

特供三博特sanplatec新一代shelldish 贝壳型细胞培养皿
图片尺寸500x965
3.倾注法:取少许含菌材料放入无菌培养皿中,倾注已融化的48&
图片尺寸554x470
关于培养皿浙江康瑟恩生物科技有限公司
图片尺寸1080x1439
培养皿在使用时也有很多需要注意的哦~991,使用前经过清洁消毒
图片尺寸1080x810
实验1 微生物学实验常用仪器洗涤及干热灭菌__ppt
图片尺寸1080x810
1 微生物的基本培养技术 同步练习-在线组卷网
图片尺寸427x206
步骤①中待倒入的培养基冷却后盖上培养皿的皿盖 c.
图片尺寸491x125
我们培养瓶和培养皿都是重复使用的,每次都是用到顶面写不下字了才会
图片尺寸1080x1080
比克曼生物一次性无菌塑料培养皿9060mm细菌细胞方形培养皿实验室
图片尺寸800x800
装液体培养基用于微生物的振荡培养1试管微生物实验中使用到哪些瓶皿
图片尺寸500x335
pc塑料耐高温培养皿90*20可多次重复使用实验室器皿
图片尺寸790x1000
还不能忽视对应培养基的使用方式
图片尺寸500x370
进口美国parafilm正品实验室白酒封口膜 pm996 10cm*38m封酒膜
图片尺寸750x999
移液管培养皿和移液管照片
图片尺寸403x300
55mm可重复使用接触碟接触皿培养皿表面皿表面微生物取样用 透明
图片尺寸800x436
培养皿 载玻片 盖玻片
图片尺寸1080x810
科学家使用在实验室的培养皿
图片尺寸700x467
美国首届微生物培养皿艺术大赛ppt模板
图片尺寸1200x5800
本作品全称为《蓝色卡通风手绘培养皿创意元素》,使用 adobe
图片尺寸780x780
【本生生物】细胞培养皿的正确使用方法
图片尺寸671x429